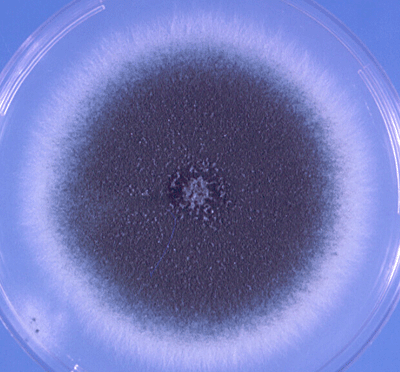
- colonies of A.fumigatus with typical blue-green surface pigmentation on Czapek doxagar(Source)﻿

Aspergillus is a ubiquitous mold found throughout the world in air, soil, water, and decaying vegetation. It is an opportunistic pathogen causing infections mainly in people with impaired immunity (people living with HIV/AIDS, having chronic infections, under steroids or immunosuppressive regimen, etc). There are more than 250 species of Aspergillus, of them, four do have clinical importance:
- Aspergillus fumigatus
- Aspergillus niger (black pigment)
- Aspergillus flavus (yellow pigment)
- Aspergillus terreus
Aspergillus fumigatus causes infections of the skin, eyes, ears, and other organs; fungus balls in the lungs, and allergic bronchopulmonary aspergillosis.
Major characteristics ofAspergillus fumigatus

- Aspergillusspecies exist only as molds, they are not dimorphic.
- Highly aerobic in nature
- They have septate hyphae that form dichotomous branches (lateral and/or apical branches the same width as the parent hyphae from which they were derived)emerging at ~Ā 45-degree angles from the parent hyphae(i.e. acute angle branching).
- The walls of the hyphae are more or less parallel, in contrast to Mucor and Rhizopuswalls, which are irregular.
- The conidia ofAspergillusform radiating chains in contrast to those of MucorandRhizopus*,*which are enclosed within a sporangium.

Pathogenesis and clinical findings
Aspergillus grows in decaying vegetation producing chains of conidia. Transmission is by inhalation of airborne conidia.
| Name of the Disease | People at risk |
|---|---|
| Allergic bronchopulmonary aspergillosis | Atopic individuals (may resemble asthma) |
| Allergic sinusitis | Atopic individuals |
| Intracavitary aspergilloma (fungus ball) | People having pre-existing pulmonary cavities because of tuberculosis or cystic disease |
| Invasive pulmonary aspergillosis | Patients with neutropenia, chronic granulomatous disease (CGD) and severely immunocompromised individuals |
| Endocarditis | Immunosuppressed patients who have undergone open-heart surgery |
| Cutaneous aspergillosis | Associated with surgical wounds or burns |
Aspergillus binds to fibrinogen and laminin in the alveolar basement membrane. Macrophages are able to ingest and kill the conidia but the organism produces gliotoxin which may inhibit phagocytosis.
Neutrophils can adhere and kill the hyphae. If neutrophils are overwhelmed by more numbers of hyphae, they may invade pulmonary and vascular tissue leading to thrombosis and necrosis which may lead to hematogenous spread (to other organs including brain).
Aspergillus fumigatus can colonize and later invade abraded skin, wounds, burns, the cornea, the external ear and paranasal sinuses. It is the most common cause of fungal sinusitis. In immunocompromised patients especially those with neutropenia, it can invade the lungs and other organs causing invasive aspergillosis.
Aspergilli are well known for their ability to grow in cavities in lungs, especially cavities caused by tuberculosis. Within the cavities, they produce an aspergilloma **āfungus ballā,**which can be seen on X-ray as a radiopaque structure that changes its position when the patient is moved from an erect to a supine position.
Allergic bronchopulmonary aspergillosis (ABPA) is an infection of the bronchi by Aspergillus species. Patient with ABPA has asthmatic symptoms with a high IgE titeragainst Aspergillus antigens, and they expectorate bronchial plugs containing hyphae.
Laboratory Diagnosis
**Sample:**Sputum, bronchial washings, and tracheal aspirates from patients with pulmonary disease and tissue biopsies from patients with disseminated disease.
Direct Microscopic Examination: Biopsy specimen shows septate, branching hyphae invading tissue. Ā KOH preparation of sputum, bronchoalveolar lavage, transbronchial biopsy, and other biopsies reveal non-pigmented septate hyphae, 3-5 um in diameter with characteristic dichotomous branching.Ā The hyphae have a tendency to branch repeatedly. The branches arise at an angle of approximately 45 degrees.

Culture: Culture is regarded as the āGold Standard Methodā. Clinical specimens should be inoculated onto primary isolation media, like Sabouraudās dextrose agar. Colonies are fast-growing and may be white, yellow, yellow-brown, brown to black, or green in color. Microscopically, cultures show colonies with characteristic radiating chains of conidia. However, positive cultures from a non-sterile specimen, such as sputum, do not prove disease because colonization is common.
Antigen detection: Several antigen tests for the detection of Aspergillus from blood, urine and CFS are now available. In a person with invasive aspergillosis, there may be high titers ofgalactomannan antigenin serum.Ā As galactomannan is rapidly eliminated from the blood, serial screening twice weekly is recommended for optimal diagnosis.
Antibody detection (serology): Immunodiffusion tests for the detection of antibodies to Aspergillus species have proven to be of value in the diagnosis of allergic, aspergilloma, and invasive aspergillosis. Patient with ABPA has high levels of IgE specific for Aspergillus antigens. IgG precipitins are also present.
Treatment
For the treatment of invasive aspergillosis, voriconazole is the drug of choice, and liposomal amphotericin B, posaconazole, caspofungin, and isavuconazonium are alternative drugs. A fungus ball growing in a sinus or in a pulmonary cavity can be surgically removed. Patients with ABPA can be treated with corticosteroids and antifungal agents, such as itraconazole.
References and further reading
- Aspergillus- The University of Adelaide
- Laboratory methods in Basic Mycology in Bailey & Scottās Diagnostic Microbiology, Forbes, 11th edition